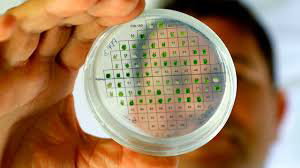

ສາຍການບິນຂອງນານາປະເທດເລີ່ມກັບມາໃຫ້ບໍລິການຖ້ຽວບິນໄປຍັງປະເທດ ສປ ຈີນອີກຄັ້ງ ຫຼັງຈາກລັດຖະບານຈີນປະກາດຜ່ອນຄາຍຂໍ້ຈຳກັດການເດີນທາງທາງອາກາດເພື່ອຄວບຄຸມການແຜ່ລະບາດຂອງເຊື້ອໂຄວິດ-19.

ບໍລິສັດການຢາອິນເດຍ ເປີດເຜີຍວ່າ: ໄດ້ອະນຸມັດ ໃຫ້ທົດລອງຢາປ້ອງກັນ (ວັກແຊງ) ພະຍາດໂຄວິດ-19 ຊື່ງເປັນຢາທີ່ຜະລິດດ້ວຍຕົນເອງພາຍໃນປະເທດເປັນຊຸດທຳອິດ.

ການລົງທຶນເຂົ້າພະລັງງານສະອາດເພື່ອຮັບໃຊ້ໃຫ້ແກ່ການຟື້ນຟູເສດຖະກິດໄລຍະຫຼັງໂຄວິດ–19 ຢູ່ອາຊີຕາເວັນອອກສ່ຽງໃຕ້(ອາຊຽນ) ຫຼາຍກ່ວາ 5 ຕື້ໂດລາສະຫະລັດ.

ທະນາຄານການລົງທຶນໃນ ໂຄງສ້າງພື້ນຖານແຫ່ງອາຊີ (AIIB) ອະນຸມັດງເງິນກູ້ຈຳນວນ 1 ຕື້ໂດລາສະຫະລັດໃຫ້ແກ່ອິນໂດ ເນເຊຍ ສຳລັບໃຊ້ໃນ 2 ໂຄງການ ແລະກະຕຸ້ນເສດຖະກິດໃຫ້ຟື້ນຕົວຈາກຜົນກະທົບທີ່ເນື່ອງມາຈາກ ການແຜ່ລະບາດຂອງເຊືອພະຍາດໂຄວິດ-19.

ມຽນມາເລີ່ມການກໍ່ສ້າງທ່າເຮືອນໍ້າເລິກເຈາະພະຍູໃນລັດຍະໄຂ່ພາຍໃຕ້ຄວາມຮ່ວມມືຈາກລັດຖະບານ ສປ ຈີນ ເພື່ອຮອງຮັບເສັ້ນທາງການຄ້າອອກສູ່ມະຫາສະໝຸດອິນ ເດຍຈາກມົນທົນຢູນນານຕາມໂຄງການໜຶ່ງແຖບໜຶ່ງເສັ້ນທາງ.

ສສ ຫວຽດນາມ ວາງແຜນຫຼຸດພາສີນໍ້າມັນເຮືອບິນລົງ 30% ເພື່ອຊ່ວຍເຫຼືອສາຍການບິນທ້ອງຖິ່ນຝ່າວິກິດການແຜ່ລະບາດຂອງພະຍາດໂຄວິດ-19.
ຕາມຂ່າວຕ່າງປະເທດລາຍງານວ່າ ລັດຖະບານຫວຽດນາມວາງແຜນປັບຫຼຸດພາສີນໍ້າມັນເຊື້ອໄຟສຳລັບເຮືອບິນລົງ 30% ເພື່ອຊ່ວຍເຫຼືອສາຍການບິນ

ວັນທີ 26 ມິຖຸນາທີ່ຜ່ານມາໄດ້ເກີດເຫດຟ້າຜ່າຢູ່ອິນເດຍເຮັດໃຫ້ມີຜູ້ເສຍຊີວິດ 100 ກວ່າຄົນ ໃນພື້ນທີ່ລັດພິຫານ ແລະລັດອຸດຕະປະເທດ.

ສະໜາມບິນ ອໍລີ (Orly Airport) ທາງພາກໃຕ້ຂອງຝຮັ່ງເປີດໃຫ້ບໍລິການອີກຄັ້ງໃນວັນທີ 26 ມິຖຸນານີ້ຫຼັງຈາກປິດໃຫ້ບໍລິການຕັ້ງແຕ່ທ້າຍເດືອນມີນາ ເນື່ອງຈາກໂຄວິດ-19 ແຜ່ລະບາດຢ່າງໜັກ.

ທ່ານ ໂດນັລ ທຣຳ ປະທານາທິບໍດີຂອງອາເມລິກາເລັ່ງເກັບພາສີນໍາເຂົ້າອາຫານທະເລ ສປ ຈີນ ຖ້າຫາກພົບວ່າບໍ່ປະຕິບັດຕາມຂໍ້ຕົກລົງການຄ້າຊຸດທຳອິດ ຫວັງໃຊ້ໂອກາດປ້ອງກັນທຸລະກິດສົ່ງອອກກຸ້ງລ໊ອບສະເຕີອາເມລິກາ.
ການຊອກຫາພະລັງງານທາງເລືອກທີ່ເປັນມິດກັບສິ່ງແວດລ້ອມ ແລະໃຊ້ງານໄດ້ຢ່າງຍືນຍົງເປັນສິ່ງທີ່ນັກວິໄຈພະຍາຍາມຄິດຄົ້ນ ແລະພັດທະນາຢ່າງຕໍ່ເນື່ອງແລະດົນນານ ຈຸດໝາຍຕົ້ນຕໍກໍຄືເພື່ອນໍາມາທົດແທນການໃຊ້ພະລັງງານຈາກຊາກດຶກດຳບັນ(ຟອສຊິລ)ຄື: ນໍ້າມັນດິບ, ຖ່ານຫີນ, ແກ໊ສ